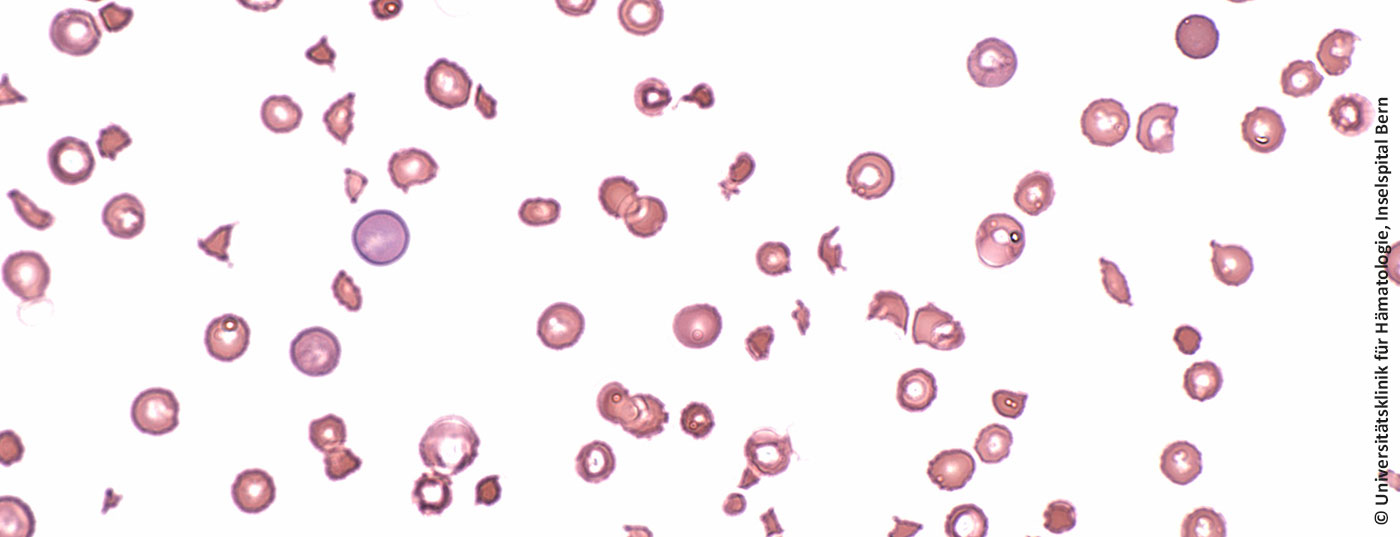
ttp_blutbild

Die Autoimmunerkrankung TTP ist selten, lebensbedrohlich und schwer zu behandeln. Die Ergebnisse einer grossen Phase III-Studie unter Mitwirkung des Inselspitals Bern lenken nun die Aufmerksamkeit auf eine neue Therapieoption: Caplacizumab.
Die Autoimmunerkrankung TTP ist selten, lebensbedrohlich und schwer zu behandeln. Die Ergebnisse einer grossen Phase III-Studie unter Mitwirkung des Inselspitals Bern lenken nun die Aufmerksamkeit auf eine neue Therapieoption: Caplacizumab.
Gib dein Suchwort ein und drücke Enter.
